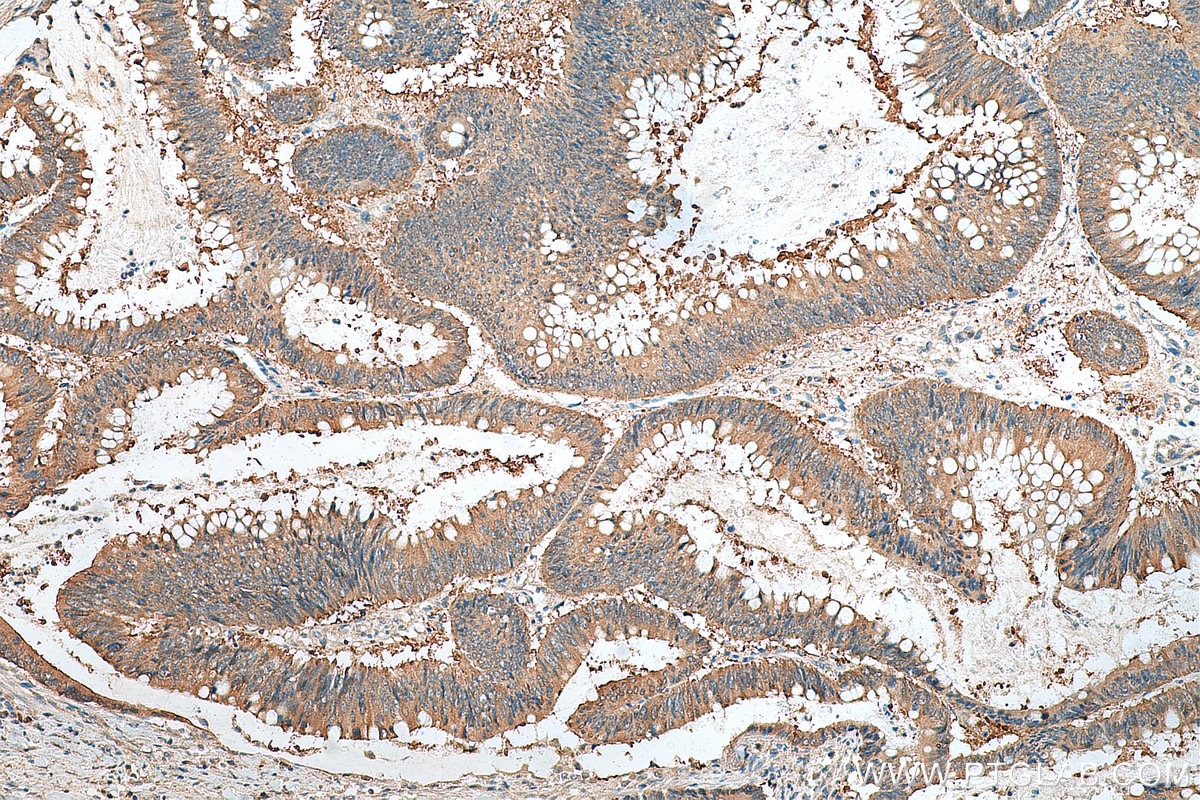
Immunohistochemical analysis of paraffin-embedded human colon cancer tissue slide using 14732-1-AP (hD53; TPD52L1 antibody) at dilution of 1:200 (under 10x lens). Heat mediated antigen retrieval with Tris-EDTA buffer (pH 9.0). Immunohistochemistry (IHC) staining of human colon cancer tissue using hD53; TPD52L1 Polyclonal antibody (14732-1-AP)
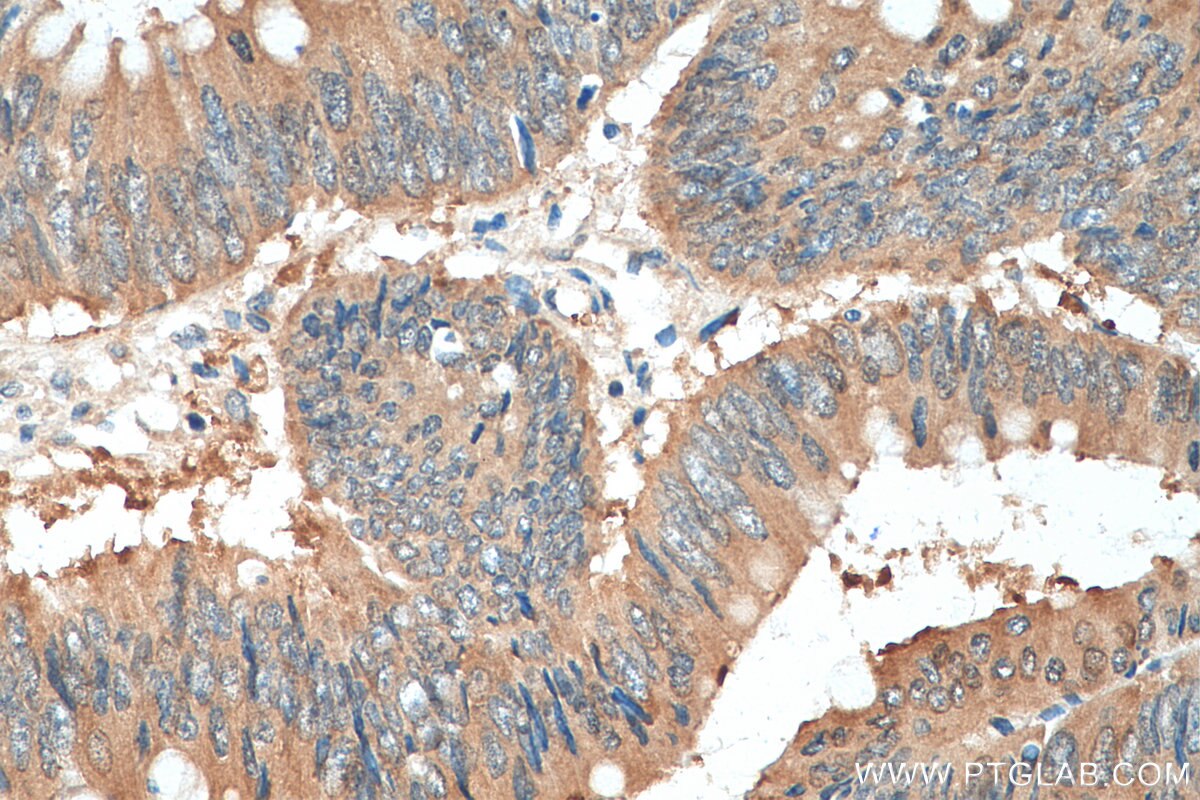
Immunohistochemical analysis of paraffin-embedded human colon cancer tissue slide using 14732-1-AP (hD53; TPD52L1 antibody) at dilution of 1:200 (under 40x lens). Heat mediated antigen retrieval with Tris-EDTA buffer (pH 9.0). Immunohistochemistry (IHC) staining of human colon cancer tissue using hD53; TPD52L1 Polyclonal antibody (14732-1-AP)

Tested Applications
| Positive WB detected in | MCF7 cells, MCF-7 cells |
| Positive IP detected in | MCF-7 cells |
| Positive IHC detected in | human colon cancer tissue, human prostate cancer tissue Note: suggested antigen retrieval with TE buffer pH 9.0; (*) Alternatively, antigen retrieval may be performed with citrate buffer pH 6.0 |
| Positive IF/ICC detected in | MCF-7 cells |
Recommended dilution
| Application | Dilution |
|---|---|
| Western Blot (WB) | WB : 1:500-1:1000 |
| Immunoprecipitation (IP) | IP : 0.5-4.0 ug for 1.0-3.0 mg of total protein lysate |
| Immunohistochemistry (IHC) | IHC : 1:50-1:500 |
| Immunofluorescence (IF)/ICC | IF/ICC : 1:20-1:200 |
| It is recommended that this reagent should be titrated in each testing system to obtain optimal results. | |
| Sample-dependent, Check data in validation data gallery. | |
Published Applications
| WB | See 4 publications below |
| IHC | See 3 publications below |
| IP | See 1 publications below |
Product Information
14732-1-AP targets hD53; TPD52L1 in WB, IHC, IF/ICC, IP, ELISA applications and shows reactivity with human samples.
| Tested Reactivity | human |
| Cited Reactivity | human, mouse |
| Host / Isotype | Rabbit / IgG |
| Class | Polyclonal |
| Type | Antibody |
| Immunogen |
CatNo: Ag6493 Product name: Recombinant human hD53; TPD52L1 protein Source: e coli.-derived, PGEX-4T Tag: GST Domain: 1-144 aa of BC002375 Sequence: MEAQAQGLLETEPLQGTDEDAVASADFSSMLSEEEKEELKAELVQLEDEITTLRQVLSAKERHLVEIKQKLGMNLMNELKQNFSKSWHDMQTTTAYKKTHETLSHAGQKATAAFSNVGTAISKKFGDMSYSIRHSISMPAMRRK Predict reactive species |
| Full Name | tumor protein D52-like 1 |
| Calculated Molecular Weight | 22 kDa |
| Observed Molecular Weight | 25 kDa |
| GenBank Accession Number | BC002375 |
| Gene Symbol | TPD52L1 |
| Gene ID (NCBI) | 7164 |
| RRID | AB_2272159 |
| Conjugate | Unconjugated |
| Form | Liquid |
| Purification Method | Antigen affinity purification |
| UNIPROT ID | Q16890 |
| Storage Buffer | PBS with 0.02% sodium azide and 50% glycerol, pH 7.3. |
| Storage Conditions | Store at -20°C. Stable for one year after shipment. Aliquoting is unnecessary for -20oC storage. 20ul sizes contain 0.1% BSA. |
Background Information
Tumor protein D52-like 1 (TPD52L1) gene, also known as hD53, encodes a member of the tumor protein D52 (TPD52) family. TPD52-like proteins are coiled-coil motif-bearing proteins first identified through their expression in human breast carcinoma, which have been proposed to represent signaling intermediates and regulators of vesicle trafficking. hD53 may form homo- or heterodimers with other TPD52 family members, and it is reported to be involved in cell proliferation and calcium signaling. Four variants resulted from alternative splicing have been predicated and this antibody is expected to recognize all the variants.
Protocols
| Product Specific Protocols | |
|---|---|
| IF protocol for hD53; TPD52L1 antibody 14732-1-AP | Download protocol |
| IHC protocol for hD53; TPD52L1 antibody 14732-1-AP | Download protocol |
| IP protocol for hD53; TPD52L1 antibody 14732-1-AP | Download protocol |
| WB protocol for hD53; TPD52L1 antibody 14732-1-AP | Download protocol |
| Standard Protocols | |
|---|---|
| Click here to view our Standard Protocols |
Publications
| Species | Application | Title |
|---|---|---|
Cell Biosci Tumor protein D52 is upregulated in oral squamous carcinoma cells under hypoxia in a hypoxia-inducible-factor-independent manner and is involved in cell death resistance. | ||
Front Oncol Transcriptomic Analyses of the Adenoma-Carcinoma Sequence Identify Hallmarks Associated With the Onset of Colorectal Cancer. | ||
Int J Oncol Opposite effects of tumor protein D (TPD) 52 and TPD54 on oral squamous cell carcinoma cells. | ||
Biochem J Tumor protein D52 expression is post-transcriptionally regulated by T-cell intercellular antigen (TIA) 1 and TIA-related protein via mRNA stability. | ||
Biomedicines Tumor Protein D53 (TPD53): Involvement in Malignant Transformation of Low-Malignant Oral Squamous Cell Carcinoma Cells | ||
Sci Data The Signaling Pathways Project, an integrated 'omics knowledgebase for mammalian cellular signaling pathways. |